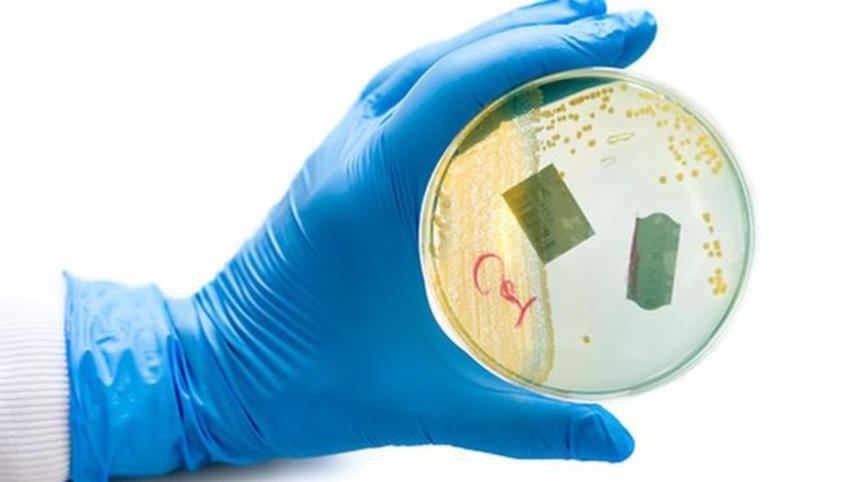
Bacteria-UTI-SequencingWB.jpg

Hope for faster treatment of urinary tract infections
Urinary tract infections can be treated more quickly using a new DNA sequencing device, according to research.
Scientists from the University of East Anglia (UEA) say the device - the size of a USB stick - can detect bacteria directly from urine samples four times more quickly than traditional methods.
The technology could lead to faster treatment and better use of antibiotics, they say.
The findings were unveiled at a medical conference in San Diego.
Prof David Livermore, from UEA's Norwich Medical School, said there was a need to move beyond the current "carpet-bombing" approach to treating urinary tract infections (UTIs).
"The way to do so lies in accelerating laboratory investigation, so that treatment can be refined earlier, benefitting the patient, who gets an effective antibiotic, and society, whose diminishing stock of antibiotics is better managed," he said.
The device can also detect resistance to antibiotics, said Dr Justin O'Grady, also from UEA's Norwich Medical School.
"Swift results like these will make it possible to refine a patient's treatment much earlier - and that's good for the patient, who gets the 'right' antibiotic, and for society - which can better manage or 'steward' its limited supply of antibiotics," he said.
There were still challenges to overcome as the technique only works on heavily infected urine, he added.
Superbugs are now a major global health threat with multi-drug resistant bacteria causing around 400,000 infections and 25,000 deaths in Europe every year.



 For all latest news, follow The Daily Star's Google News channel.
For all latest news, follow The Daily Star's Google News channel.
Comments